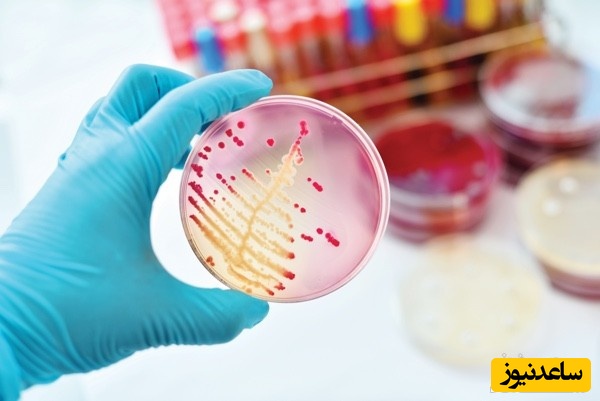
نمونه کارنامه و ظرفیت پذیرش رشته میکروب شناسی پزشکی در مقطع کارشناسی ارشد

به گزارش سرویس دانشگاه پایگاه خبری ساعدنیوز، میکروب به معنی موجود زنده ریز است. امروزه میکروب شناسی به یک علم تخصصی تبدیل شده که مجموعه ی بزرگی از ارگانیسم های بسیار متنوع را شامل می شود. امروزه میکروب شناسی گرایش های متعددی دارد، از جمله: میکروب شناسی مولکولی، میکروب شناسی کاربردی، میکروب شناسی صنعتی، میکروب شناسی غذایی، میکروب شناسی محیطی، میکروب شناسی پزشکی و ...
در ادامه چند نمونه کارنامه قبولی در گرایشات مختلف این رشته در مقطع کارشناسی ارشد را برای متقاضیان قبولی در این رشته قرار داده ایم.




دانشگاه | دولتی | دوره شهریه پرداز | جمع کل |
اراک | 4 | 4 | 8 |
اردبیل | 4 | 0 | 4 |
ارومیه | 4 | 4 | 8 |
اصفهان | 4 | 3 | 7 |
البرز | 4 | 3 | 7 |
انستیتوپاستور ایران | 6 | 0 | 6 |
اهواز | 5 | 0 | 5 |
ایران | 7 | 0 | 7 |
ایلام | 4 | 3 | 7 |
بابل | 4 | 3 | 7 |
بقیه اله | 3 | 0 | 3 |
بوشهر | 4 | 3 | 7 |
تبریز | 4 | 3 | 7 |
تهران | 9 | 0 | 9 |
دانشگاه تربیت مدرس | 6 | 3 | 9 |
دانشگاه شاهد | 3 | 4 | 7 |
زاهدان | 4 | 3 | 7 |
زنجان | 4 | 3 | 7 |
شهرکرد | 4 | 4 | 8 |
شهیدبهشتی | 5 | 4 | 9 |
شیراز | 6 | 0 | 6 |
قزوین | 4 | 3 | 7 |
کردستان | 4 | 3 | 7 |
کرمان | 5 | 0 | 5 |
کرمانشاه | 4 | 4 | 8 |
گلستان | 4 | 3 | 7 |
گیلان | 4 | 0 | 4 |
مازندران | 4 | 0 | 4 |
مشهد | 4 | 3 | 7 |
موسسه سرم سازی رازی | 4 | 0 | 4 |
همدان | 5 | 3 | 8 |
یاسوج | 4 | 0 | 4 |
یزد | 3 | 3 | 6 |
جمع کل | 147 | 69 | 216 |